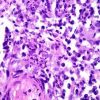

-
 0 +1
0 +1Bodyguard: Recap and Thoughts for an American Audience – Instabamm
A recap of Bodyguard’s first episode, and the reasons why I’m already hooked. Richard Madden is David Budd, a damaged war vet turned elite cop.
-
 +8 +2
+8 +2Julian Assange should be thanked - not smeared - for Wikileaks' service to journalism
Twelve years ago this month, WikiLeaks began publishing government secrets that the world public might otherwise never have known. What it has revealed about state duplicity, human rights abuses and corruption goes beyond anything published in the world’s “mainstream” media. After over six months of being cut off from outside world, on 14 October Ecuador has partly restored Wikileaks founder Julian Assange’s communications with the outside world from its London embassy where the founder has been living for over six years.
-
 +9 +1
+9 +1Sainsbury's To Launch New 'Affordable' Vegan Meat Brand In Stores Across UK
Major supermarket Sainsbury's is launching new vegan meat products in stores across the UK this month. The products - mince and burgers - are made by plant-based startup The Meatless Farm Co and described by the company as 'competitively priced' at RRP £3.00 and £2.50 respectively. They are one of many recent plant-based launches for Sainsbury's, as it caters to growing consumer demand for vegetarian and vegan food.
-
 +21 +3
+21 +3Royal College of Psychiatrists to review opposition to decriminalising cannabis
The Royal College of Psychiatrists is to review its opposition to the legalisation of cannabis. The organisation has been wary of moves to decriminalise the drug because of concerns of possible negative effects on users' health. There is also an association between psychotic illnesses and high-strength varieties of the drug.
-
 +28 +7
+28 +7Medical cannabis to be available on UK prescription within weeks
There was medical cannabis news out today in the UK. It emerged that within the next month, it will be available on prescription. Currently cannabis-derived medicines are only prescribed in exceptional circumstances and a medical panel has to agree. The latest move represents a shift in the tone and the procedure by the government's Home Office.
-
 +10 +1
+10 +1Police drone finds girl, 16, who called 999 to report rape
A teenage girl who did not know where she was and called 999 to report that a man had raped her was found after police deployed a drone equipped with a thermal imaging camera. The 16-year-old called emergency services in the early hours of Saturday to say she was on land somewhere in Boston, Lincolnshire, with her attacker.
-
 +20 +2
+20 +2Amazon raises minimum wage for US and UK employees
Amazon has raised its minimum wage for British and American workers, in a major milestone for campaigners pushing for pay increases to tackle rising levels of poverty and inequality. The company, which has become almost a byword for low-paid and low-quality work in recent years, said it would increase the minimum wage to $15 (£11.57) an hour in the US for more than 350,000 workers, while almost 40,000 staff in Britain will get an increase to £10.50 an hour in London and £9.50 across the rest of the country.
-
 +21 +4
+21 +4Hundreds of academics at top UK universities accused of bullying
Senior professors among 300 people alleged to have bullied students and colleagues
-
 +11 +2
+11 +2A 3rd Russian agent reportedly went to England to prep the nerve agent attack on Sergei Skripal
British authorities have identified a third agent involved in the attack against former Russian spy Sergei Skripal, The Telegraph reported. The UK earlier this month accused two Russian intelligence agents over the attempted assassination. The Kremlin repeatedly denied knowledge of the attack.
-
 +21 +5
+21 +5The chances of a second Brexit referendum just got higher
The chances of Britain holding a second referendum on Brexit just got higher. Britain's opposition Labour party voted overwhelmingly Tuesday for a policy that would put a new vote on the table if Prime Minister Theresa May failed to get an eventual Brexit deal through the UK Parliament. And Labour's Brexit spokesman, Keir Starmer, received rapturous applause at his party's annual conference when he raised the prospect that staying in the European Union would be on the ballot paper.
-
 +15 +2
+15 +2May 'humiliated' after EU leaders reject latest Brexit plan, British media say
British Prime Minister Theresa May said Friday the European Union must come up with an alternative to her Brexit proposals, noting that talks had reached an impasse after bloc leaders had rejected her plans without explaining why. "It's not acceptable to simply reject the other side's proposals without a detailed explanation and counter proposals," May said in a televised statement.
-
 +20 +2
+20 +2Internet regulator considered for UK
The UK government is considering "all options", including a regulator, as part of new legislation governing the internet. It has previously said it will publish a White Paper in the coming months, laying out its proposals. According to Buzzfeed News, the White Paper will propose a regulatory body similar to Ofcom, which regulates broadcasters and telecoms companies. The government told the BBC it would publish the White Paper this winter. But a spokesman for the department for Digital, Culture, Media and Sport (DCMS) said it had nothing to share at this time.
-
 +16 +4
+16 +4Most Britons ready to vote for new centre-ground party amid Tory and Labour chaos, new poll finds
A majority of Britons would now consider voting for a new centre-ground political movement amid soaring dismay at the state of the main parties, an exclusive poll has revealed. The exclusive research for The Independent found the number of those ready to back a new party has leapt in just four months after a summer in which Labour’s antisemitism crisis raged and the Tories tore themselves apart over Brexit.
-
 +28 +3
+28 +3Native bee species could be 'wiped out' as Asian hornets spread across UK, conservationists warn
Britain's native bee species face being “wiped out” by a "highly aggressive" Asian hornet, conservationists have warned after the invasive insect was spotted in two locations at opposite ends of the country. The honey bee-killing Asian hornet, which is believed to have first arrived in Europe on crates imported from China to France in 2004, has been confirmed at locations in Liskeard, Cornwall and Hull. The creature, which is smaller than the UK's native hornet, poses no greater risk to humans than the humble wasp, but feasts on honey bees and is capable of killing around 50 a day.
-
 +17 +4
+17 +4Planes, trains and perfume: how CCTV tracked Novichok to the Skripal's door
Britain is one of the most heavily surveilled nations on Earth. And then there are the 'super recognisers'. This is how they found their men.
-
 +17 +3
+17 +3This is how climate change affects cows in the dairy industry
The unusually hot summer of 2018 has proved challenging for farmers across the UK. Among other things, the scorching weather and lack of rain has damaged crops, and the grass used to feed farm animals too. Unfortunately the unusual may become more usual as the effects of climate change are felt more frequently across the world. The high ambient temperatures and humidity seen this year, as well as extreme weather conditions such as flooding, are a significant challenge to the future of farming.
-
 +23 +3
+23 +3Silver Coins Lead to One of the Earliest Roman Sites in Yorkshire
The dig site found by metal detectorists 3 years ago appears to be a high-status homestead that once had two villas
-
 +10 +3
+10 +3Brexit: Theresa May claims trade deal success in Africa – but critics say it's a 'rollover' of existing EU agreement
Theresa May has come under fire for claiming to have secured the UK’s first post-Brexit trade deal as it is merely a “rollover” of an existing EU agreement. Critics said the announcement – to replicate a deal with six southern African nations – fell far short of boasts, before the referendum, of a new free trade area much larger than the EU. They also pointed out that it came amid doubts about whether the UK will be able to retain deals the EU has struck recently with Canada and Japan – which are far bigger economies.
-
 +10 +1
+10 +1'Flesh-eating' STD reported in UK for first time
Most UK and US cases occur after patients have unprotected sex in endemic countries.
-
+1 +1
+1 +1Flesh-eating STI which causes genitals to 'rot away' found in UK for first time
A sexually transmitted disease which causes the genitals to erupt into flesh-eating ulcers has been detected for the first time in the UK and it's making a comeback in other countries too. Usually found in far-flung tropical countries, there have been no previous cases of the rare STI Donovanosis recorded in the UK. That is until now.
Submit a link
Start a discussion




















